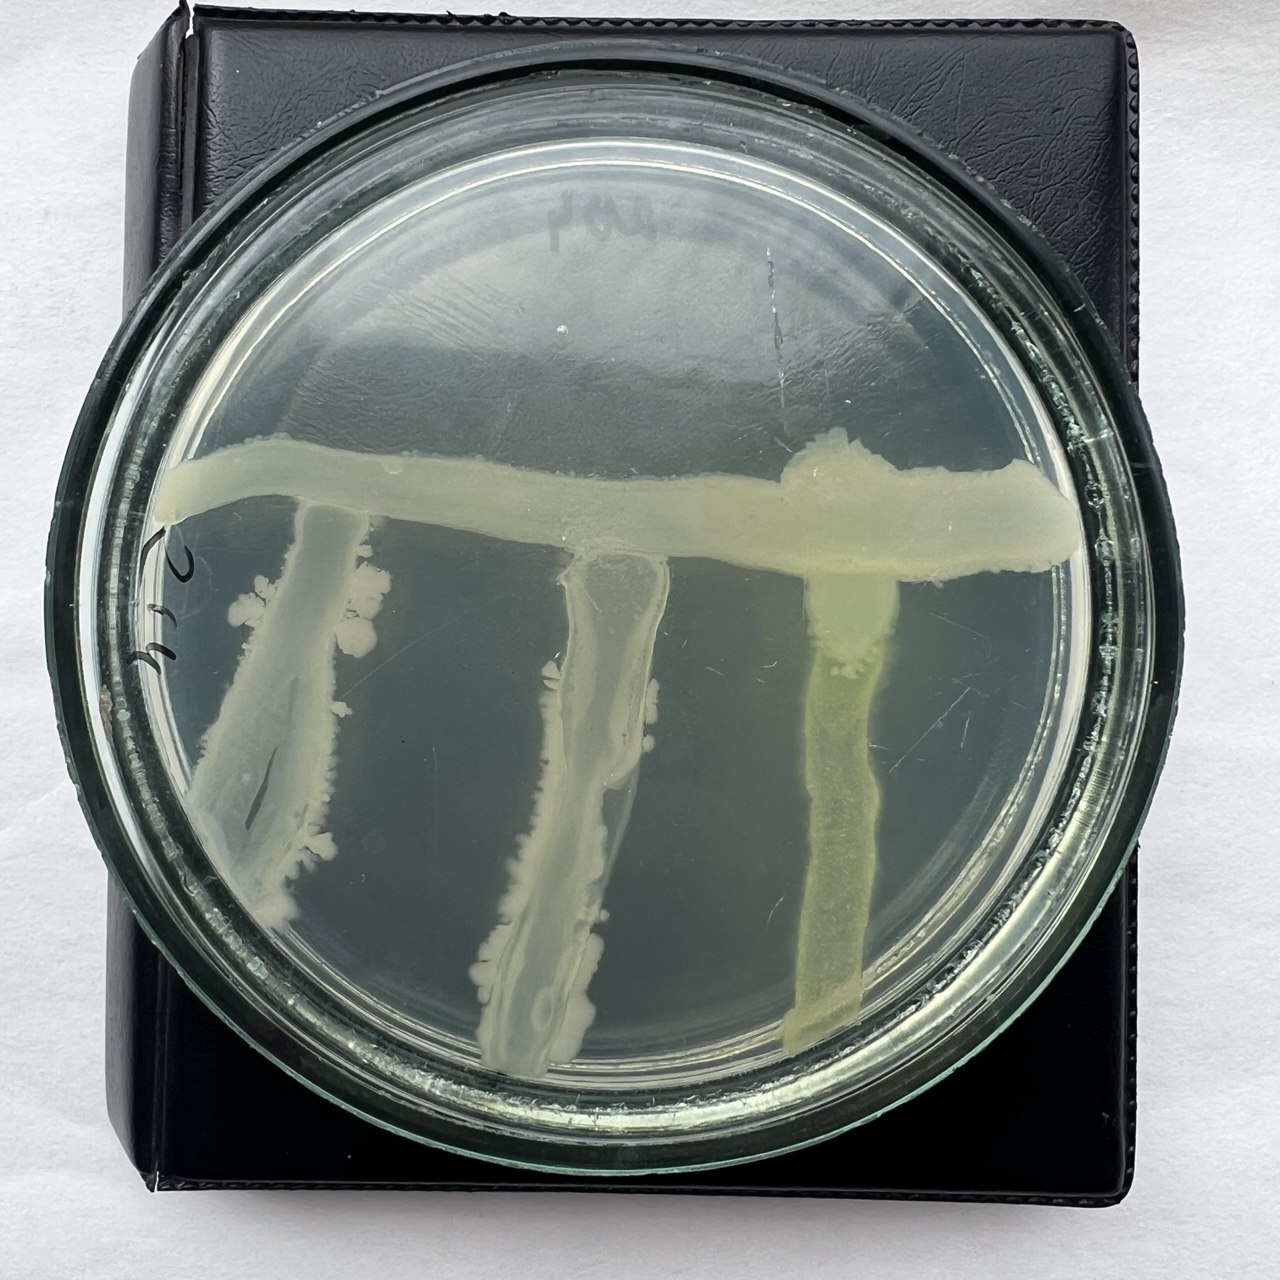

Впервые в Российской Федерации вышел на этап государственной регистрации многокомпонентный микробиологический препарат. Речь идет о препарате нового поколения «Микробиоком-Агро». Это результат многолетней работы микробиологов Научно-исследовательского института сельского хозяйства Крыма.
Препарат регулирует минеральное питание сельскохозяйственных культур, защищает их от бактериальных и грибных инфекций, стимулирует рост и развитие, повышает продуктивность и качество растениеводческой продукции. Его уникальность в том, что работу выполняют четыре рода бактерий с разной функциональностью, которые усиливают действие друг друга, а главное, они включаются в работу в нужный момент во время роста и развития растения.

Препарат прошел регистрационные испытания в 4 российских регионах (Тамбовская, Самарская области, Ставропольский и Краснодарский край) в части биологической эффективности на 9 сельскохозяйственных культурах (пшеница, соя, подсолнечник, рапс, томаты, огурец, капуста белокочанная, смородина, яблоня) и на всех получен отличный результат.
Обработка препаратом семян повысила урожайность полевых культур на 5,8-26%. Урожайность томатов возросла до 19,4 %, капусты — на 12,6 %, огурца на 13-16%. Стимулирующее действие препарата показано в увеличение количества однолетних побегов и средней длины годичного прироста у смородины (на 48,6 см) и яблони (на 34,2–37,7 см).

Регистрация препарата – важный и необходимый этап на пути расширения производства и широкого внедрения препарата.
Препарат универсален и повышает экономическую эффективность самого широкого спектра культур от 5 до 12 тыс. рублей на гектар. Помимо увеличения объемов урожая повышает и его качество: содержание белка в зерне сои; клейковины, протеинов – в зерне пшеницы, жира – в семенах подсолнечника; витамина С и сахаров в плодах овощных культур. Конечно же, значима экологическая безопасность уникального крымского препарата, — отметила кандидат сельскохозяйственных наук, ведущий научный сотрудник отдела сельскохозяйственной микробиологии НИИСХ Крыма Ирина Каменева.
Марина ПАВЛОВА
Фото пресс-службы НИИСХ Крыма













